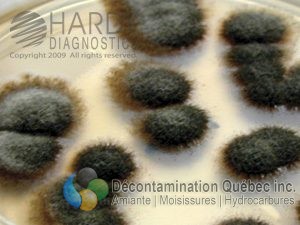
Décontamination Qc

― Basé sur le diaporama de Stachybotrys chartarum
Par: Rodérick Bouchard
B.Sc., Microbiologiste Agréé
Dans cet article, nous explorerons plus en détails le genre de moisissure Stachybotrys, en particulier l’espèce chartarum. L’Institut National de Santé Publique du Québec (INSPQ) a identifié cette espèce en particulier comme une cause de problème de santé dans les maisons où elle se retrouve. C’est pourquoi nous explorerons ce sujet dans cet article.
Stachybotrys chartarum, communément appelée « moisissure noire », est soit de cette couleur ou soit verdâtre. À noter que malgré ce nom commun, elle n’est pas la seule moisissure noire, comme vous pouvez voir dans les articles portant sur Penicillium, Aspergillus ou Cladosporium. Dans la nature, on retrouve le S. chartarum dans le sol et elle est répertoriée partout dans le monde. Ensuite, c’est un mycète qui se nourrit principalement de cellulose, constituant des cellules végétales. Elle n’a pas de préférence pour trouver cette cellulose, ce qui fait que l’on peut la retrouver dans plusieurs milieux, tant que ceux-ci ont cette composante en quantité suffisante. Pour donner quelques exemples, on peut retrouver S. chartarum dans les milieux suivants :
Cette moisissure n’est pas très compétitive avec les autres, étant donné que ces exigences de croissance faisant en sorte qu’elle ne prolifère pas très vite non plus.

Aperçu de ce qu’aurait l’air une infestation de S. chartarum

La masse de conidies de S. chartarum au bout du conidiophore. On peut presque voir tout le phialide. La gélatine a été enlevé par le fixatif. Observé au microscope électronique.
S. chartarum grandissante sur un milieu sélectif

S. chartarum vue au microscope à objecti
D’abord, Stachybotrys chartarum peut croître à des températures variant entre 2°C et 41°C. Elle atteint une croissance optimale entre 23°C et 27°C. Ensuite, elle a besoin d’un milieu fortement humide pour se développer. En outre, elle prend plus de temps que la plupart des autres moisissures dans son procédé de développement. En effet, la plupart des moisissures prennent 24h à développer des spores en milieu humide, celle-ci en prendra 48h. Finalement, elle a besoin d’un taux activité d’eau fort pour se développer. Dans le cas de S. chartarum, le minimum est de 0,94 et il croit de façon optimale à 0,98.
La littérature reconnait que certaines toxines produites par Stachybotrys chartarum peuvent entraîner des problèmes de santé chez les animaux. En ce qui concerne les êtres humains, les études n’ont pas encore été faites mais, on pense qu’elles seraient neurotoxiques pour nous. Voici quelques exemples de symptômes reportés par des gens ayant été en contact avec un milieu comportant cette moisissure:
La gravité des symptômes listés ci-dessus peut varier selon certains facteurs tels que la durée d’exposition et à la sensibilité du sujet par exemple.

Forte croissance de S. chartarum et d’autres champignons sur un panneau mural de gypse dans un sous-sol de l’école inondée. Cette croissance s’est produite environ une semaine après l’inondation. Ce panneau a été retiré avant le remodelage

Croissance de S. chartarum sur un revêtement de papier (flèche ci-dessus) isolant en fibre de verre. Ce papier touchait l’autre qui couvrait le revêtement de plâtre au plafond, résultant en une croissance excessive de moisissures. Le bâtiment avait une fuite de toiture qui s’égouttait sur le plafond et sur l’isolation.

Croissance de S. chartarum à l’arrière du panneau mural de gypse endommagé par l’eau derrière une cabine de douche en sous-sol. Une nappe phréatique élevée a causé des inondations dans le sous-sol
En premier lieu, faites une inspection visuelle de la maison pour voir si vous voyez des traces noires ou verdâtres. En effet, ce genre de marques comme sur les photos et du matériel endommagé sont de bon indice de sa présence. Ensuite, utilisez votre odorat pour voir si une pièce dégage une odeur de terre ou de moisi. S. chartarum par son métabolisme libère des produits organiques volatiles. Finalement, regardez si un occupant de la maison a des symptômes similaires à ceux nommé ci-dessus.
Nous espérons que cet article vous en a un peu plus appris sur Stachybotrys chartarum. Si vous avez des doutes que votre habitation contienne de la moisissure ou pour toute autre question concernant ce sujet, nous pourrons faire une évaluation à savoir s’il y a bien présence de S. chartarum ou d’autres genres de moisissures avec les tests appropriés à votre domicile. Notre équipe de professionnel sait comment confirmer la présence de moisissure et éliminer celle-ci sans risque pour votre santé.
Vous pouvez nous joindre par téléphone au (418) 476-0360 ou par courriel à infos@decontaminationquebec.com. Il nous fera plaisir de vous aider.